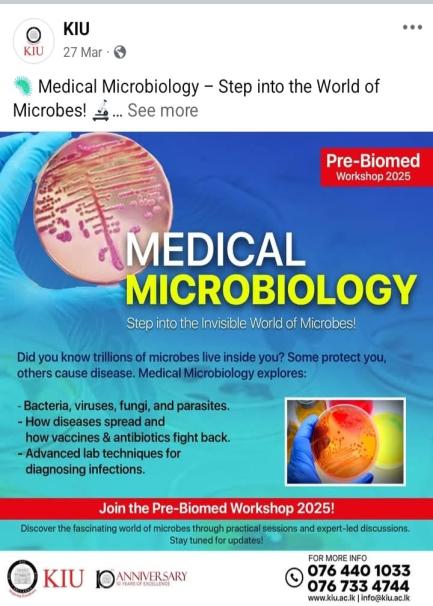

At the Faculty of Health Science, we are committed to nurturing skilled, research-oriented, and industry-ready graduates who can contribute effectively to the healthcare sector. Our annual workshop series goes beyond classroom learning, providing students with opportunities to build strong research skills, gain hands-on experience through laboratory and healthcare field visits, and participate in specialized departmental activities.
The Acupuncture Department focuses on practical clinical training and community engagement. Students gain hands-on experience through clinical sessions conducted at the Acupuncture Clinic. The department also organizes leaflet campaigns as part of its outreach and marketing initiatives to raise awareness about acupuncture practices.
Annual Signature Workshops
Our continuous workshop series includes:
· Research Workshops – Focused sessions to build essential research skills for undergraduate and postgraduate students.
· Research Proposal Writing – Training students to structure, develop, and present impactful research proposals.
· Literature Review Writing – Guiding students to conduct thorough literature searches and write critical reviews.
· Research Article Writing – Helping students understand the structure and process of writing publishable research articles.
· Laboratory Hands‑On Practical Workshops – Providing students with real-time, practical experience in laboratory techniques, safety procedures, and essential laboratory sector skills.
10th Youth- APT Workshop- Minuwangoda president college